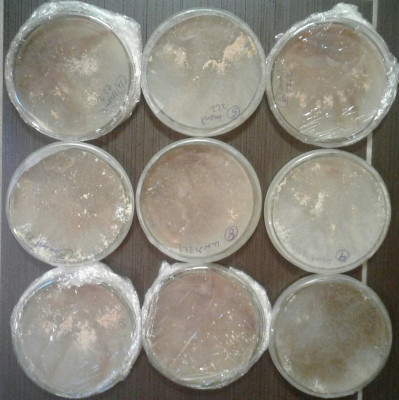
20210305_173447-3-1.jpg (1.37 MiB) 10737 mal betrachtet Die Impfstelle liegt auf 12 Uhr

Seite 4 von 7
Re: Morchelbrut
Verfasst: Mittwoch, 03. März 2021 19:29
von elfi
Ich schaue später wieder vorbei

Re: Morchelbrut
Verfasst: Mittwoch, 03. März 2021 20:18
von Mycomane
Hallo Elfi,
herzlich Willkommen im Forum!
Schön, dass du auch zu uns gestoßen bist.
Und freue mich auf folgende Beiträge von dir.
LG, Fabian
Re: Morchelbrut
Verfasst: Mittwoch, 03. März 2021 20:49
von elfi
Hallo und guten Abend.
Gela hat mich hergelotst.
Vielleicht kann ich euch ein bisschen helfen.
Re: Morchelbrut
Verfasst: Mittwoch, 03. März 2021 20:51
von elfi
Im Moment habe ich noch ein Problem mit dem Händeln des Forums. zB. Bilder einstellen
Re: Morchelbrut
Verfasst: Mittwoch, 03. März 2021 21:00
von elfi
Muss mich noch schlau machen auch ein Portät erstellen, das dauert noch
Ich habe einfach den Link von Gela übernommen, aber das muss ich noch richtg machen.
Re: Morchelbrut
Verfasst: Mittwoch, 03. März 2021 21:02
von Mycomane
Wenn du einen Beitrag erstellst, kannst du unter dem Bereich zum Eingeben des Textes neben "Options" auf "Attachments" klicken.
Dann darunter auf "Add files", und dann kannst du von deinem Computer die Bilder aussuchen, die du hochladen möchtest.
Hoffe das hat dir geholfen. Ansonsten frag einfach nochmal genauer nach.
LG, Fabian
Re: Morchelbrut
Verfasst: Mittwoch, 03. März 2021 21:04
von Mycomane
Nimm dir einfach etwas Zeit. Ist doch kein Problem.
Bei konkreten Fragen kann dir sicherlich geholfen werden.
LG, Fabian
Re: Morchelbrut
Verfasst: Mittwoch, 03. März 2021 21:10
von Mycomane
Was das Porträt angeht, bzw. das Bild dafür, sollte es glaube ich die richtige Größe haben.
Falls du kein Bildbearbeitungsprogramm hast, mit dem du die Bildgröße anpassen kannst, frag einfach nochmal nach.
Ansonsten schau dich erstmal etwas um und probiere aus, wie du die Einstellungen ändern kannst.
LG, Fabian
Re: Morchelbrut
Verfasst: Mittwoch, 03. März 2021 23:25
von mariapilz
Hallo elfi!
Ich hätte bitte gerne den Schlüssel
Spass! ....Aber. .. Fragen wir mal ins blaue. ..
Was könnte für welche Morchel der Auslöser zum Fruchtkörper bilden sein?
Die Chinesen haben bei der Outdoor Züchtung mit dem Proben zu kämpfen, dass auf einem Acker wo 2-3 Jahre Morcheln kultiviert wurden plötzlich keine mehr wachsen. Wiso? ... oder anders... wachsen auf deinen Morchelplätzen jedes Jahr (vorausgesetzt das wetter/Regen passt) immer wieder Morcheln? + wächst dort immer die gleiche Morchelart?
Sonstige Auffälligkeiten Vermutungen?
Wir sind hier sehr geduldig und gemütlich. Ein paar sind philosophisch angehaucht, aber die sind nicht bissig.

Keine Hektik
liebe grüße
Re: Morchelbrut
Verfasst: Donnerstag, 04. März 2021 20:52
von elfi
Hallo Maria,
eben habe ich dir eine Antwort geschrieben , die ich nicht mehr finde .
Nun eine Kurzfassung:
In all den Pflanzen oder Untergründen steckt MANGAN drin.
Auch in den Spitzmorcheln selbst.
Beste Grüße
Elfi
Re: Morchelbrut
Verfasst: Donnerstag, 04. März 2021 21:41
von Gela
Hallo zusammen,
Elfi hat mir ihr ok gegeben, aus ihrem Buch „Pilzfieber“ die Seiten über Morcheln hier einzustellen.
Anbei als Fotos.
Elfi ist für Diskussionen immer zu haben. Bitte Seitenreihenfolge beachten.
Liebe Grüße, die Gela
Re: Morchelbrut
Verfasst: Freitag, 05. März 2021 09:25
von mariapilz
Danke! Mangan... Das gehört getestet. Da ich kein chemiefreak bin, muss man noch recherchieren, wie man am besten Mangan zuführt bzw. welche quelle man nutzen kann, die auch gut mengenmäßig messbar ist. Da man nicht weiß wieviel Mangan in der jeweiligen Asche ist....
Re: Morchelbrut
Verfasst: Freitag, 05. März 2021 15:21
von elfi
Hallo Maria,
wenn du Mangan auftreiben kannst, musst du einfach Versuche machen.
Wichtig für das M.-Wachstum ist auch die Bodenfeuchtigkeit.
Bei Pestwurz bin ich der Meinung, dass die Morcheln mit ihr eine Svmbiose eingehen.
Wenn es der Pestwurz zu trocken wird verschwinden die Morcheln. 2 Jahre später ist die Pestwurz weg.
Oft wird sie von Weißer Pestwurz ersetzt, doch bei der wachsen keine Morcheln.
Morcheln wolle es feucht, aber keine nassen Füße!
Re: Morchelbrut
Verfasst: Freitag, 05. März 2021 16:59
von Mycomane
Hallo ihr Lieben!
Vielen Dank Elfi, dass wir in dein Buch Einsicht nehmen dürfen.
Das mit dem Mangan finde ich eine interessante Sache.
So eine Anmerkung was Mangan angeht hatten wir hier schon einmal im Forum, vor langer langer Zeit.
Kann mir gut vorstellen, dass Morcheln eine besondere Vorliebe für Mangan haben.
Werde beizeiten versuchen die Veröffentlichung zu lesen die du zu dem Mangan gefunden hast.
Dass Asche im Allgemeine gut sein wird, davon bin ich auch überzeugt.
Maria, du hast Recht, dass man im Prinzip genau wissen sollte wie viel Mangan man dazutut, wenn man sollche Versuche machen möchte.
Aber ich denke, man sollte hier etwas vorsichtig sein.
Wenn du z.B. ein gut lösliches Mangansalz nehmen würdest um es künstlich dem Substrat zugeben möchtest, dann ist es sehr leicht das zu übertreiben. Mangan ist wie auch viele andere Elemente ein Spurenelement. Auch wenn Morcheln daran einen erhöten Bedarf haben könnten, bleibt es trotzdem ein Spurenelement und kann in zu großen Mengen auch leicht gesundheitsschädlich werden.
So ist es aber auch bei anderen Spurenelementen wie Zink, Kupfer etc...
Wenn man eine schlecht lösliche Manganverbindung nimmt, wie den von Elfi angesprochenen Braunstein, dann ist die Gefahr des Überdosierens sicherlich viel geringer. Allerdings weiß ich gerade nicht genau wie löslich Braunstein nun überhaupt ist.
Das wird vermutlich auch vom pH-Wert des Bodens abhängen und von anderen Verbindungen im Boden, die freigesetzte Manganionen komplexieren können und so vielleicht in Lösung halten. Das wäre dann schon eine recht komplexe Frage.
Aber ist auf jeden Fall interessant!
LG, Fabian
Re: Morchelbrut
Verfasst: Freitag, 05. März 2021 22:28
von mariapilz
Fabian, das klingt kompliziert. Das muss ich später mal durchdenken und wahrscheinlich eine eher semi-wissenschaftliche Lösung finden müssen. Zuerst mal soweit kommen...
Gerade koche ich 12 Petris (MEA incl Pepton), denn meine 9 Sporenpetris vom 22.2 sind eigentlich schon viel zu durchwachsen (...Ich bin wohl gluckentempogeschädigt)
- Die Impfstelle liegt auf 12 Uhr
Weiters habe ich 4 kleine Marmeladengläser mit hauptsächlich Pferdescheißepellets angesetzt. Jedes Glas hat eine leicht andere Rezeptur (Kokos, Schafwollpellets, Orchideen"erde") die wurden am 1.3 mit Sporen versehen. Man sieht noch gar nichts. Ich hoffe dass ich genügend Sporen aufklauben und auch im Substrat wieder abstreifen konnte...